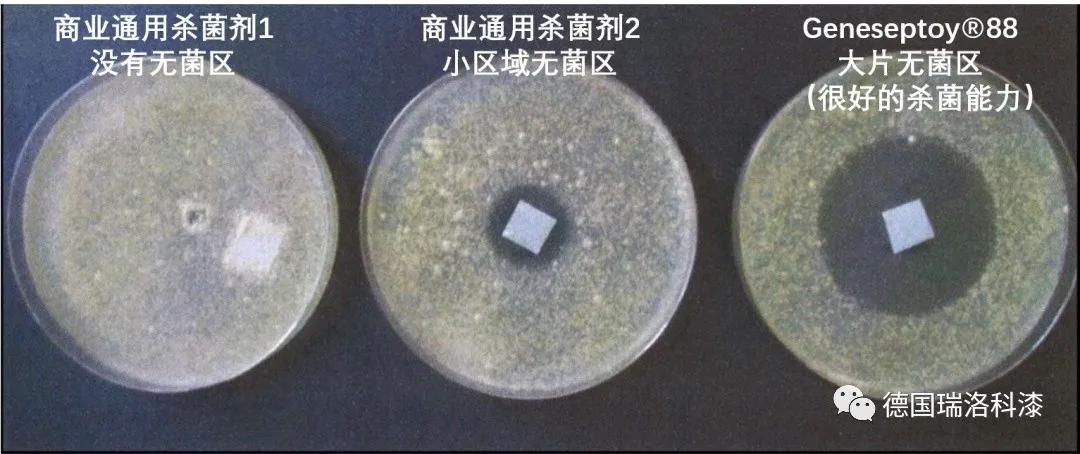
瑞洛科漆怎么样 (华润漆怎么配制)

从2018年11月进入中国市场,德国瑞洛科漆入华马上三周年了。
去年春天,正是全民抗疫的关键时期,德国瑞洛科漆以“随风潜入夜,润物细无声”的姿态活跃中国市场,为众多高端消费者带来了德国品质的健康家居生活体验。
入华三周年来,瑞洛科漆到底给中国市场带来了哪些惊喜?
NO.1
走近瑞洛科
德国品牌之所以闻名于世,是因为德国人有史以来的严谨和认真。就像汽车行业的保时捷、奔驰和宝马一样。
瑞洛科Rhenolack源自德国著名涂料品牌Rhenocoll(雷诺科)公司。公司成立于1948年,拥有73年的悠久历史。
1948年,金特·齐默曼先生在德国莱茵兰普法尔茨州创建瑞洛科(Rhenocoll)。

▲ 金特·齐默曼先生
2004年,瑞洛科Karnauba Natur新产品问世。这是世界第一款由巴西棕榈木为溶剂的纯天然涂料,对常见的花粉过敏症有显著的防治作用。

2005年,瑞洛科获得德国经济部授予的“科技创新奖”。

▲ 2005年科技创新奖
2007年,瑞洛科获得联邦总统颁发的“有益环境特殊贡献奖”。

▲ 联邦总统颁发“有益环境特殊贡献奖”
2009年,瑞洛科再次获得经济部授予“科技创新奖 。

▲ 2009科技创新奖
2015年,瑞洛科研发技术Geneseptoy@ GY 88获得世界专利。

▲ 德国创新企业100强
2017年,瑞洛科被评选为“德国创新企业100强。同年,获得“德国莱茵兰普法尔茨州科技企业创新奖”。

▲ 科技企业创新奖
2018年,瑞洛科获得化学品制造领域大奖“responsible care科技企业创新奖”。

2018年11月,中德合资公司”瑞诺科涂料(广东)有限公司”,德国“瑞洛科Rhenolack正式进入中国市场,开启了在中国市场上开疆拓土的新征程,

▲ 瑞洛科签约进入中国市场
2020年,入选中国+大装饰公司供应商集采名录。
经过70多年的发展创新,瑞洛科成为了德国最知名的涂料品牌之一。
70多年来,瑞洛科为二战后的德国飞机螺旋桨提供过专利材料,成为有飞机螺旋桨专利技术的跨国原料商而蜚声世界。
70多年来,瑞洛科致力于打造人类安全宜居的生活环境,以“严谨务实,专注技术”的德国工匠精神在产品的研发上不遗余力。
NO.2
瑞洛科技术实力
在70多年的发展历史中,瑞洛科取得了许多傲视同行的专业成就。
瑞洛科现有研发中心3个,获得了各项权威人证专利超过450个。
特别是最近20年来,瑞洛科在产品创新和技术研发方面取得的一系列卓越成就,更是让人刮目相看。

在前文讲述品牌历史时,我们已经提及瑞洛科的一些极具实力的技术奖项,在这里不再赘述,只对个别有代表性的技术进行介绍。






▲ 瑞洛科的技术研发
2015年,瑞洛科研发技术Geneseptoy® GY 88获得世界专利。
GY88是世界级抗细菌、抗霉菌专利,是墙体防菌领域中率先获得全球认证的专利技术。

世界专利Geneseptoy®GY88是一种纯天然的矿物质合成物,百分之百纯天然。
GY88以受到专利保护的特殊工艺将不同的矿物质混合微米级别的颗粒,并作为传统的有毒防腐剂的替代品使用在涂料和油漆当中,为居室提供长期有效的健康保护。
GY88绿色环保,能对墙体表面进行长效保护,时刻抵御各种细菌和霉菌的滋生,从而保护家人健康,对过敏性人群尤其适用。

▲ Geneseptoy®88纯矿物质无毒认证
作为世界独家专利,GY88将不含任何有毒物质的天然矿物岩转化为微米级别并包裹住外来入侵的霉菌,当物体中的酶不能催化转化成糖分子,入侵细菌的营养源将会被切断,细菌便没有机会继续生存,可极大改善居室的卫生状况。
测试实验显示,与通用杀菌剂相比,GY88具有大片的无菌区,杀菌功能非常强大。
▲ GY88有很强的屏蔽细菌能力
NO.3
瑞洛科品牌实力
德国瑞洛科漆在全球拥有多个现代化的生产基地。




▲ 瑞洛科生产基地
荣誉是瑞洛科不断前行的动力。
德国瑞洛科漆把“严谨务实,专注技术”的德系工匠精神延续到产品的研发上,采用天然海洋成分,不添加任何有害物质。
瑞洛科产品先后通过了“德国蓝天使”、“法国A+”、“欧盟生态标签”、“中国环保标志产品”等全球性权威认证,全方位让您家居室舒心、放心!

品牌基因决定品牌的生命力。 源自德国的生态涂料瑞洛科,致力把优秀的德系品质涂料带给中国消费者,为人们提供健康无忧的家居新体验。

强大的技术研发水平和品牌实力,让瑞洛科产品行销世界上超过75个国家,可随时为全球消费者提供服务。

瑞洛科通过进口商和专业技术顾问完成对全球各大洲的覆盖。
瑞洛科通过参加世界范围内各类专业会议和展会,让触角向全球延伸。
今天的瑞洛科漆,已经形成 了以欧洲为中心,在波兰、捷克、斯洛伐克、格鲁吉亚、匈牙利、乌克兰、俄罗斯、高加索、中东、伊朗、阿联酋、印度、智利及中国设有分公司。
NO.4
品牌定位及VI形象
德国瑞洛科漆的品牌特质:德国进口品牌,严谨务实,精工,高品质。
瑞洛科漆的品牌愿景:打造具有世界影响力的生态涂料王国。
瑞洛科漆的品牌使命:焕发多彩的家居生活。
瑞洛科漆的品牌广告语:源自德国的生态涂料。
瑞洛科漆的品牌价值观:用户价值第一,拥抱市场变化,与客户共赢,与奋斗者分享。
瑞洛科漆的品牌定位:德国进口品牌,德国技术,进口品牌,中国区总代,立足中国及亚太区市场,专注零售及装饰公司渠道的高端进口品牌。
瑞洛科的logo设计理念:引用联邦德国国徽雄“鹰”元素,以及德国*旗国**中的“红色“为主色,配合德文”RHENOLACK“设计而成。
瑞洛科logo的图标部分使用德文”RHENOLACK“首字母“R”为主设计,提取联邦德国国徽雄“鹰”元素,外形生动不失稳重,象征幸福、恩宠和力量。

瑞洛科logo颜色上以德国*旗国**中“红色“为主色,象征胜利、喜悦、给人以积极正向的印象。


▲ 瑞洛科漆终端形象店
NO.5
瑞洛科产品体系
德国瑞洛科漆目前在中国市上销售的内墙乳胶漆产品,有金钻抗污无添加内墙漆、金装抗菌全效内墙漆、臻品无添加内墙漆、净味环保内墙漆、室内多功能抗碱底漆、多功能调色漆六大系列产品。



▲ 瑞洛科漆部分内墙乳胶漆产品
德国瑞洛科金钻抗污无添加内墙漆,漆膜致密,可抵御多种污渍。采用抗菌技术,可持久耐菌、抑菌。具有超强防霉、抗碱功能。耐擦洗大于三万次。遮盖力强,可有效弥盖细微裂纹。
德国瑞洛科臻品无添加内墙漆,不添加APEO、重金属。防霉抗碱,持久靓丽。漆膜致密,耐擦洗优异。遮盖力强,可有效弥盖细微裂纹。

▲ 德国瑞洛科臻品无添加内墙漆
德国瑞洛科室内多功能抗碱底漆,采用净味配方,低VOC。抗碱防霉持久保护。优异封闭性,防止水汽渗透。良好附着力,更易施工。

▲ 德国瑞洛科室内多功能抗碱底漆
艺术漆也是瑞洛科产品的重要组成部分。
瑞洛科柏林姿彩艺术漆进驻中国市场的新品首发,为中国消费者焕发了丰富多彩的艺术家居生活体验。
净味抗甲醛,色彩纯正、饱满,具有立体观感,皮质丝滑手感,抗污耐擦洗, 瑞洛科柏林姿彩艺术漆,成为了众多高端消费者家居装修的首选。

为满足现代消费者偏爱高品质产品的消费需求,德国瑞洛科漆道过严格的产品全阶段测试体验,带给消费者严谨的至臻品质。
NO.6
瑞洛科带来的惊喜
这么好的产品,您有没有想过自己代理经销,体验一下创业的乐趣呢?
如果您心动了,手上也有一定余钱,本身又有创业或换品牌经营的想法,何不赶紧行动呢?

如果您是涂料行业中具有高端品牌意识的经营者,或者目前经营的是杂牌,有意向经营进口品牌者;
如果您是窗帘、墙纸、墙布等软装经销商,及定制等其他建材商;
如果您是当地的家装整装公司;
如果您是80、90后有意向经营进口涂料创业者……
您就是我们要找的合作伙伴。
如果您选择了瑞洛科,我们提供的不仅仅是德国品质的中高端进口产品。
我们的营销人员还将提供专业的建店支持、渠道开发、小区推广、店面促销和招商指导等一对一的贴身服务,助您轻松实现创业梦。
近年来,随着生活水平的提高,追求个性装修的消费者越来越多,对价格和档次的要求也越来越高。这也因此助长了部分消费者对原装进口涂料的需求,价格贵一点也能接受。
正是基于这样的原因,这些年芬琳、大师等原装进口涂料一直在中国市场上占领着高端涂料较大的市场份额,虽然整体销量不大,却是尖端消费者人群的首要选择。
德国瑞洛科漆进入中国市场,也是为了满足中国高端消费人群的装修需求,以德国产品的严谨和至臻品质,给更多高端消费人群带来更多的选择。
当然,满足合作和意向合作装饰公司对原装进口涂料的需求,满足高端定制的需要,也是瑞洛科入驻中国市场的原因之一。
德国瑞洛科漆将重点发展与区域市场上前三甲装饰公司的业务合作,利用自身的优质服务体系,打造行业顶尖进口涂料品牌,满足中国市场高端消费群体的需求。
入华三周年,德国瑞洛科漆已经被业之峰、东易日盛、星艺、华浔、鲁班等众多大型装饰公司广泛使用。
去年7月,瑞洛科漆在华浔装饰(博鳌)全国会议上盛装亮相,华浔夏董亲自为瑞洛科代言。

▲ 瑞洛科漆亮相华浔装饰(博鳌)全国会议现场
与全国装饰行业知名企业陕西鲁班装饰的战略合作,也是德国瑞洛科漆引领装饰行业健康环保新风尚的杰作。这两年,陕西鲁班装饰每次进货都会订购至少5000桶德国瑞洛科漆。

▲ 鲁班装饰进瑞洛科漆5000桶
瑞洛科艺术漆除了与星艺装饰、鲁班装饰达成战略合作外,经过前期的成功试用,也即将与业之峰装饰达成战略合作。
不得不承认,入华三周年的德国瑞洛科漆,的确给中国市场带来了惊喜。